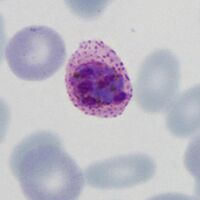
Early small form note James' dots
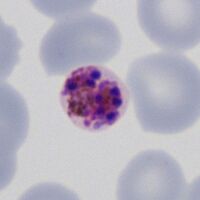
Late form prior to merozoite release

Gallery of schizonts
From MalariaETC
Navigation
>Main Malaria Index
>>Galleries Index Page
>>>Current page: Gallery of schizonts
Gallery of Schizonts
Schizont morphology is variable as they divide their chromatin into separate distinct separate masses (usually a schizont is defined by have more than two masses to distinguish them from rings that have double dots). This morphological variability then continues through successive divisions and maturation. Despite this however, some features such as erythocyte size and shape, added dots, pigment distribution and the number of merozoites present can still be useful (as can the fact that they are rarely seen in P.falciparum.
P.falciparum
Loose and often "tatty" appearances with 16 or more merozoites and clumped pigment when mature. Rare in blood as they sequester in tissues and circulating form may appear degenerate. Images show mature forms.
-
Variable merozoite number, clumped pigment
-
Degenerate small merozoite
-
Large merozoites
-
Large merozoites
"
P.vivax
Charactertically large and Schüffner's dots may be seen. The merozoites tend to pack the red cell with numbers up to 16-32 in mature merozoites. Pigment has diffuse distribution. Images show a maturing sequence.
-
Early form with separate chromatin but no individual merozoites
-
Similar to previous, note Schüffner's dots
-
Maturing form with separate merozoites
-
Large mature form, note patchy pigment
"
P.ovale
Share many features with P.vivax and may not be easy to distinguish, tend not to be as large with fewer merozoites (up to 16). Ovoid shape and fimbriation of red cells may be present together with James' dots. Pigment has a patchy distribution.
-
Early small form note James' dots
-
Early form, merozoites still form a single mass
-
Small mature form with separated merozoites
-
Mature larger form, note ovoid shape
"
P.malariae
Small and often neat parasites with few merozoites when mature (generally around 8-12). Often there is a central clump of pigment with merozoites arranged around this (daisy head appearance).
-
Early schizont with multiple chromatin dots
-
A daisy with merozoites around central pigment
-
A less well formed daisy, note small size
-
Late form prior to merozoite release
"
P.knowlesi
Similar in appearance to P.malariae. The forms tend to be small with relatively few merozoites present. Pigment tend to form a clump.
-
Early form with few chromatin masses
-
Almost a daisy with central clumped pigment
-
Prior to release of merozoites
-
Immediately before merozoite release